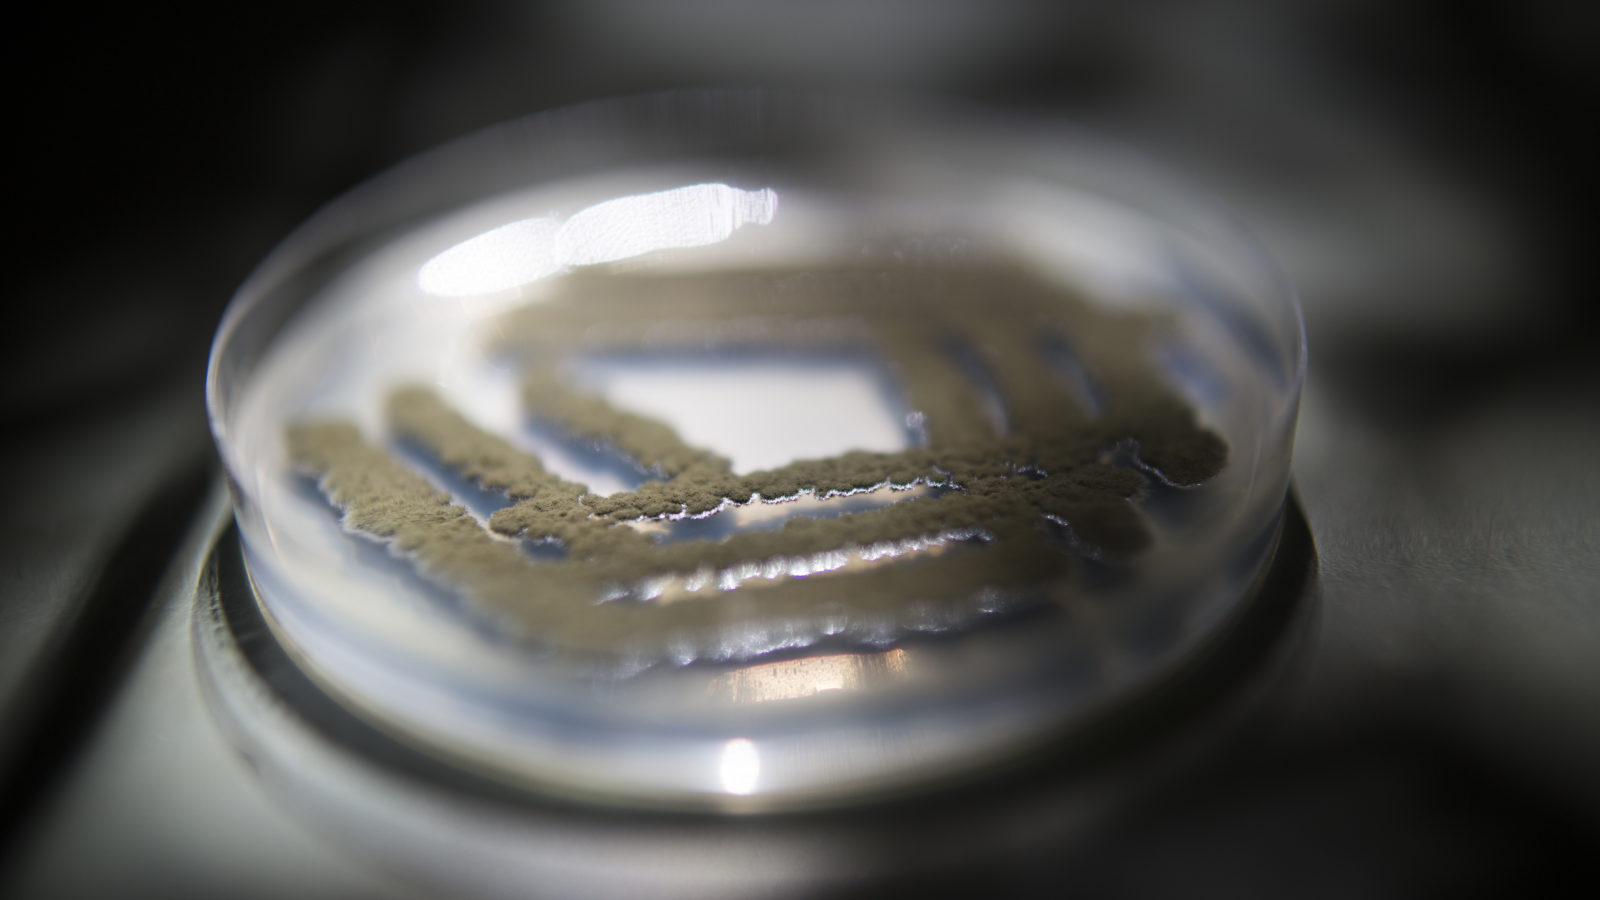

作者 SHAYLA LOVE
图片由JENNA SCHOENEFELD为STAT提供
2016年10月11日
加利福尼亚州帕萨迪纳市的喷气推进实验室(the Jet Propulsion Laboratory)里,经历过一次太空旅行的球孢枝孢霉菌在皮氏培养皿中生长
8月26日,“龙”号太空舱坠落于墨西哥下加利福尼亚沿岸某处的太平洋海面。舱内载有的真菌,已经历过人类所知的两种最极端的生长条件:外太空和切尔诺贝利核电站。
这些真菌具有抗辐射性。三十年前,当进行一次引起整个北乌克兰放射性爆炸的常规检测时,它们存活了下来。美国航空航天局(NASA)喷气推进实验室的一名科学家Kasthuri Venkateswaran及南加州大学药学院(the USC School of Pharmacy)的一位教授Clay Wang,将这些真菌送往国际空间站(International Space Station),试图促使它们再一次适应生存环境。
太空舱着陆那天,Venkateswaran和Wang驾车一小时来到加州长滩收集这些样品,他们将装有真菌的柱形管放入了冷却箱内。在实验室,他们用了过去一个月的时间来研究这趟旅程使真菌发生的改变。他们希望能利用这些具有强大复原力的有机体,研发出能赋予人体相似复原力的药物,比如用于癌症治疗的药物。但想要形成一种不同的空间隐喻,这只是一小步而已。

Kasthuri Venkateswaran在加利福尼亚州帕萨迪纳市的喷气推进实验室
从90年代末开始,这种霉菌就一直由Tamas Torok保管。他在加州劳伦斯伯克利国家实验室的研究室里,存有超过2000种从切尔诺贝利及周边地区采集的真菌。这些存于零下80摄氏度的真菌,被及时地冰冻贮藏以维持它们的基因组成。
位于基辅的微生物和病毒研究所(the Institute of Microbiology and Virology in Kiev)的微生物学家NelliZhdanova和她的同事最初在爆炸数十年后,用机器人采集了一些样品。他们发现在这个有史以来最严重的核事故现场,微生物的生长出乎意料地旺盛。
她的团队发现这些真菌不仅可以在30公里禁区内生存,一些距离辐射源很近的品种还表现出了令人惊叹的能力。Torok表示:“一旦这些真菌发现了辐射源,它们会径直朝着那个方向生长。这是一项全新的发现,以前从未有人见过。”
进一步测试表明,这些真菌的黑色素表达水平更高,这种色素使得我们的毛发和皮肤有颜色,并能够吸收辐射。由于黑色素作用,距离核反应堆最近的真菌呈深黑色,但是距离反应堆越远,黑色素表达水平越低。
爱因斯坦医学院(Albert Einstein College of Medicine)最近一项研究有了进一步发现。科学家发现切尔诺贝利真菌实际上是借助辐射,将一般具有致命性的伽马射线转变成了一种能量来源。

NASA喷气推进实验室里,被送往国际空间站的切尔诺贝利真菌在皮氏培养皿中生长
这项研究引起了Venkateswaran的注意,他在NASA的一部分工作就是防止实验之外的微生物进入太空。出于这个缘故,他非常关注那些对强辐射具有耐受性的微生物,因为它们可能会在太空飞行中存活下来,并污染其他星球或小行星。同时,Venkateswaran也知道,当微生物进入太空,它们的基因表达可能会被极大地影响。
Wang在他南加州大学的实验室里,研究用天然产物制造药物的途径。四月,两人一起将构巢曲霉的四个菌株送往国际空间站,从而回答一个基本问题:“这些真菌是否会产生新物质”。Wang拒绝在结果发表前透露细节,但据说他们已经在美军产生的物质中发现了明确的分子结构改变。
Venkateswaran说:“那时我们想到,不如把这种耐辐射的真菌也送到空间站看它会如何生长?”
Venkateswaran是太空生物学的专家,Wang则帮他对所有发现的物质进行分离、鉴别及纯化。如果他们能确定这种真菌受更强的辐射作用产生的新化合物,理论上就可以将这些化合物转化为药物。
Venkateswaran设想,这些药物可以作为人们对辐射的“防晒霜”,比如接受放疗的癌症患者、在类似切尔诺贝利的核电站工作的人,或者长期飞行的NASA宇航员。
现在已有类似的防辐射药物,但美国癌症协会(the American Cancer Society)将它们视作一个活跃的研究领域。
真菌在生产有益药物方面有据可循。它们产生的“次级代谢物”可以被转化为药物。这类物质并非真菌基本生命活动所必须的,但在一定生长时期可以产生。我们已经对许多次级代谢物进行过利用改造:第一种抗生素,青霉素,是真菌杀灭细菌时产生的;洛伐他汀是许多降胆固醇药物中的有效成分;环孢霉素是器官移植中使用的一种免疫抑制剂。这些都是由真菌产生的化合物。
Wang认为,在真菌基因组中隐藏的为表达的可利用代谢物是不计其数的。在一个真菌中,有400到500个基因是隐性的,但得到新的代谢物需要一定的环境压力,也许是微重力之类的条件。

球孢枝孢霉菌是研究人员正在进行基因测序的八种真菌之一
7月18日,八种切尔诺贝利真菌被送入了太空。它们被贮藏在低温容器中,在安全进入微重力环境之前不会形成芽孢。之后,国际空间站的宇航员将它们置于室温环境,经过7天或14天的生长周期后,重新放回冷藏室。
现在,这些真菌回到了帕萨迪纳Venkateswaran的实验室。过去一个月里,Venkateswaran和Wang对它们进行培养和一系列的基因测序,以探究经历过太空旅行后,它们的基因表达发生了怎样的变化。
Venkateswaran说:“虽然通过太空飞行寻找新的药用化合物是一种激动人心的方式,但这可能不会成为药物研发的常见途径。”国际空间站的商业使用越来越多,但那里只有六位科学家,他们的时间和空间都有限。
由于这些真菌有约10,000个基因,太空中抑制或促进它们表达的因素也尚不明确,因此要预测结果是非常困难的。也就是说,要确定将菌种送入太空的顺序,以及它们回来后要寻找的分子结构是非常困难的。
即使Wang和Venkateswaran在真菌中找到了目的分子,要将它们转化成药物还需要一段时间。他们的下一步应该是纯化样品并进行动物实验,之后通常要对代谢物的毒性进行化学调整。
Wang说:“我认为应该这样看这个项目:我们在寻找途径。借助国际空间站这个平台,我们能不能找到将产生具有某些生物效应的新化合物的途径?”
现在,这个答案还不得而知。
翻译:黄玉莹
校审:方露
原文链接:https://www.statnews.com/2016/10/11/space-fungus-drug-discovery/









留言